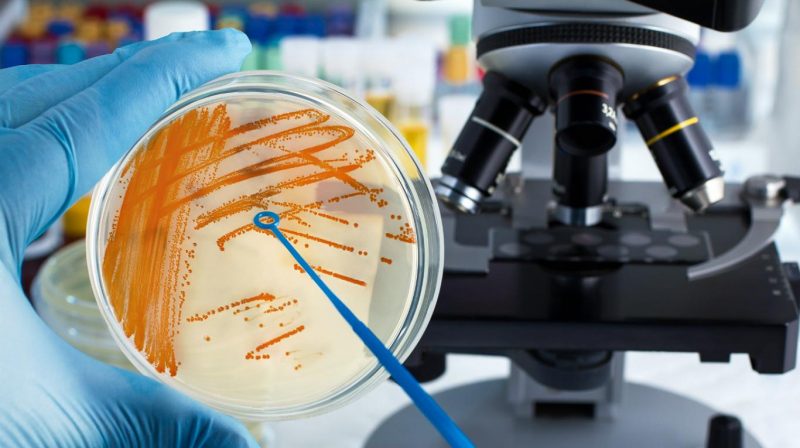

Alerta epidemiológica por una bacteria: murió una nena en Misiones
En Posadas, Misiones, una nena de 7 años llamada Luana murió el sábado en el sanatorio Caminos afectada por la bacteria Streptococcus pyogene -o estreptococo-.
Liliana Arce, jefa de Infectología del Hospital Pediátrico, señaló que hay registro de cinco pacientes pediátricos con este cuadro.
El lunes habían muerto dos chicos en el Hospital de Niños Pedro de Elizalde, en el barrio porteño de Barracas. Uno de los pacientes vivía en la ciudad de Buenos Aires y el otro en Avellaneda. A su vez, siguen internados dos de los tres que estaban, ya que uno fue dado de alta. Las edades van desde los 5 meses y de 3 a 7 años.
Hay un cuarto caso fatal en Rosario, provincia de Santa Fe.
El infectólogo pediatra Eduardo López (MN 37.586), director del Programa de Infectología Pediátrica de la UBA, buscó llevar calma a la población y descartó que se trate de una epidemia.
“Esto no es un brote y no hay vacuna que prevenga. Por eso hay que consultar con un pediatra si un chico tiene dolor de garganta, con fiebre alta y molestia para tragar; o si tiene lesiones en forma de picaduras o pequeñas lastimaduras”, explicó.
El médico aclaró que, si la bacteria de trata precozmente con antibiótico, evoluciona perfectamente y la mortalidad es bajísima. En este sentido, consideró que los chicos que murieron “fueron casos son excepcionales”.




